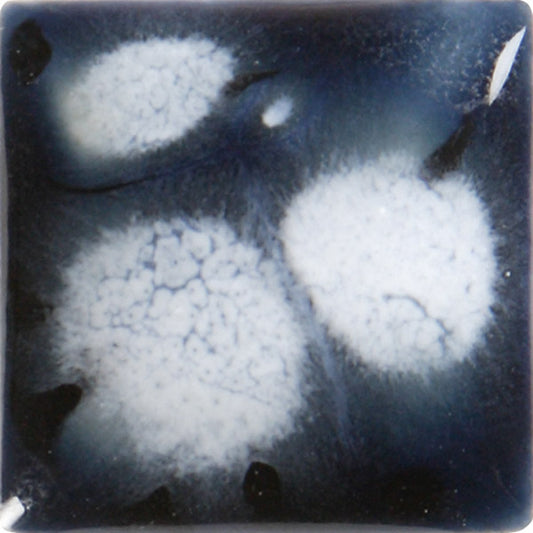
bigceramicstore-com,Duncan Crystals Glazes Blueberry Ice CR20088,Duncan,Glazes - Low-fire

-
Duncan Crystals Glazes Blueberry Ice CR20088
Regular price $15.79 USDRegular priceUnit price per$18.55 USDSale price $15.79 USDSold out -
Duncan Crystals Glazes Blueberry Ice CR20088- Pint
Regular price $17.45 USDRegular priceUnit price per -
Duncan Crystals Glazes Dalmatian CR20075
Regular price $18.55 USDRegular priceUnit price per -
Duncan Crystals Glazes Emerald Clouds CR20086
Regular price From $6.50 USDRegular priceUnit price per -
Duncan Crystals Glazes Eruption CR922-Pint
Regular price $23.69 USDRegular priceUnit price per$27.83 USDSale price $23.69 USDSale -
Duncan Crystals Glazes Harvest Time CR20091
Regular price $18.55 USDRegular priceUnit price per -
Duncan Crystals Glazes Hawaii Sand CR927 Pint
Regular price $23.09 USDRegular priceUnit price per$27.23 USDSale price $23.09 USDSale -
Duncan Crystals Glazes Monterey Jade CR20026
Regular price $6.50 USDRegular priceUnit price per -
Duncan Crystals Glazes Plum Beautiful CR20020
Regular price $6.50 USDRegular priceUnit price per -
Duncan Crystals Glazes Raspberry Ice CR20089
Regular price $18.55 USDRegular priceUnit price per -
Duncan Crystals Glazes Raspberry Lemonade CR923
Regular price $18.15 USDRegular priceUnit price per -
Duncan Crystals Glazes Sandy Beach CR926-Pint
Regular price $23.69 USDRegular priceUnit price per$27.83 USDSale price $23.69 USDSale -
Duncan Crystals Glazes Spanish Moss CR20065
Regular price $6.50 USDRegular priceUnit price per -
Duncan Crystals Glazes Wildflower Bouquet CR924
Regular price $18.55 USDRegular priceUnit price per -
Duncan Designer - One 4oz of each color (14 pcs)
Regular price $48.72 USDRegular priceUnit price per -
Duncan Designer Glaze Carbon Chiffon DG203
Regular price $6.09 USDRegular priceUnit price per$7.13 USDSale price $6.09 USDSale